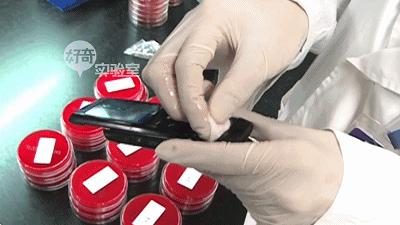
手机消毒用什么方法最好,教你如何给手机消毒又学一招
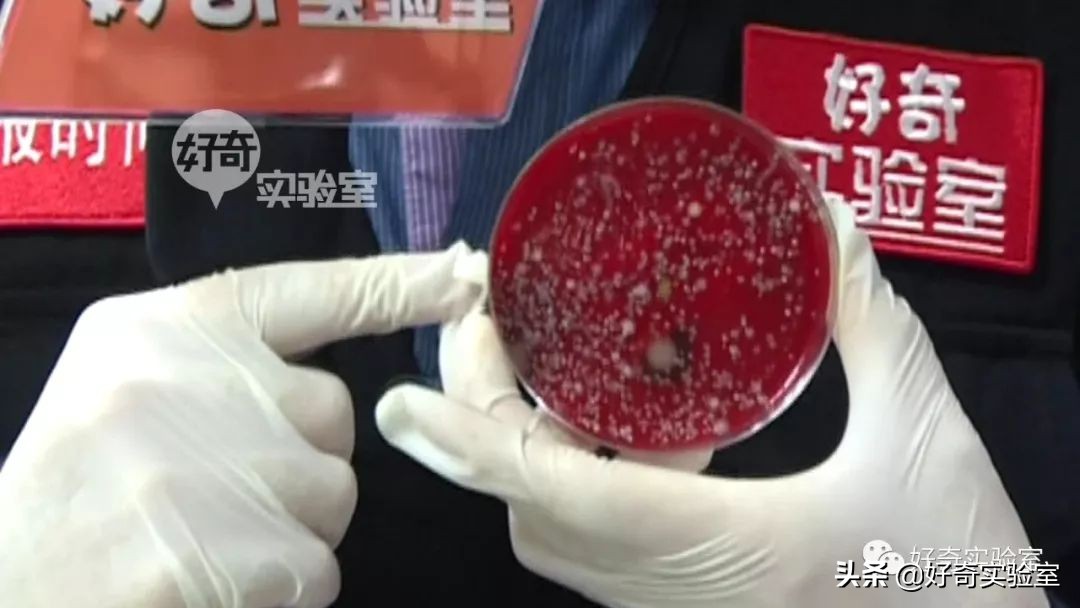
手机消毒用什么方法最好,教你如何给手机消毒又学一招
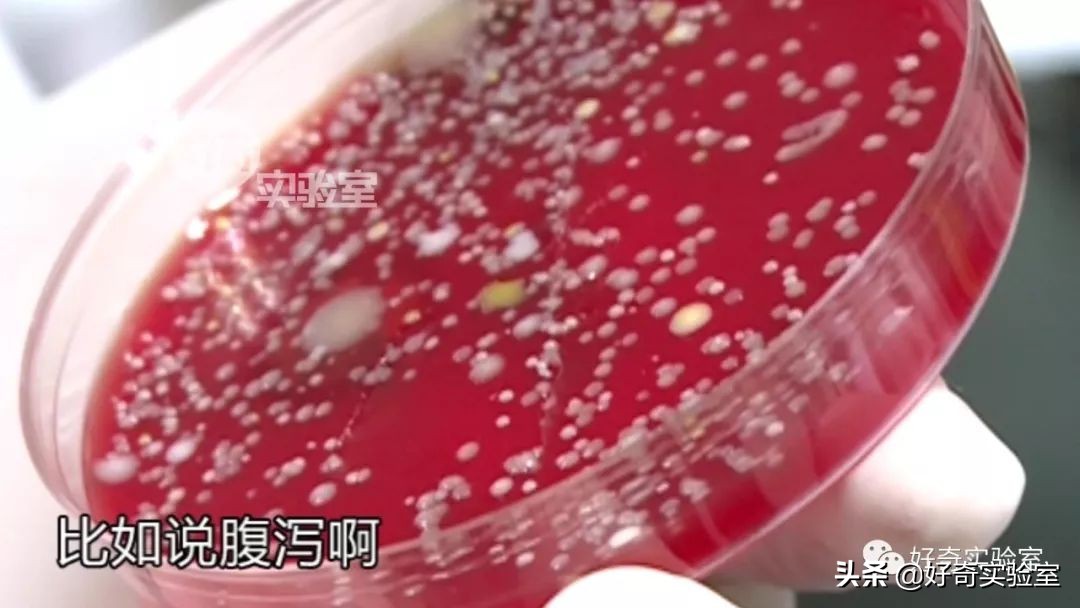
手机消毒用什么方法最好,教你如何给手机消毒又学一招

而且就算没有新冠疫情,你的手机也藏污纳垢。好奇君测过18部不同使用时间的手机,其中一部使用6年的手机细菌最多,菌落数有300个,另一部3个月的手机,菌落数只有1个,好奇君是不是给小伙伴们找了个换手机的好理由。
手机上的病菌主要有两种:表皮葡萄球菌和大肠杆菌。大肠杆菌是肠道疾病的罪魁祸首,常会引起腹泻、食物中毒等症状。而表皮葡萄球菌,可以引起我们脸上痘痘和脓包,想想手机贴在你脸上的画面,是不是有点紧张。

如果你想好好给自己的手机来一次消毒工作,动手前,不妨先了解下有哪些需要注意的部分。
01
该不该用酒精消毒手机
大部分网友会选择使用酒精消毒,直接喷洒到手机屏幕上、再用软布或纸巾擦拭,实际上这种方法并不正确。

手机属于精密电子仪器,75%的酒精也含有一部份的水,直接喷酒酒精会使部分液体,通过听筒、边框缝隙进入手机内部,损坏元器件。事实上,已经有网友晒出因此花屏的故障手机。

苹果官网的消毒指南中指出,可以使用70%异丙醇湿巾或高乐氏消毒湿巾,轻轻擦拭产品坚硬、无孔的表面。关键词“坚硬”、“无孔”非常重要。

异丙醇又名二丙醇,和酒精(乙醇)同为醇类消毒剂,可以凝固蛋白质,导致微生物死亡,属于中效消毒剂,但是因为异丙醇的气味不太好闻,所以国内使用更多的是酒精(乙醇)。

对手机来说,用酒精湿巾消毒可以起到同样目的,但要避开听筒等手机开孔的部分。

这里要特别说明一下,84消毒液的主要成分是次氯酸,对金属会有腐蚀作用,不能用来消毒手机。
02
消毒其实不复杂
我们来演示一下

1、先把手机关机。

2、去掉手机保护壳及其他饰品。

3、取适量酒精喷洒在无绒软布上,微微潮湿即可。(判断标准就是:双手挤压软布片,无酒精滴下)

4、使用无绒软布从上到下沿同一方向轻轻擦拭手机屏幕、后壳及侧边。不要擦拭手机孔、缝隙及摄像头区域,擦完不要忘了把手机壳的里外也擦一下。

5、擦拭完成后,将手机静置5分钟,等待手机表面的酒精挥发完毕后再开机。
03
酒精不会破坏疏油层
有流言说,酒精会对手机表面疏油层造成损坏,很多人不明白疏油层是做什么的,疏油层就是在屏幕上增加一层含氟的涂层。
手机屏幕上有了疏油层摩擦力更小,手指滑动更顺滑,而且不容易沾油污,留在屏幕上的指纹轻轻一擦就干干净净。

类似的情景我们可以想象一下,水滴在荷叶的状态,由于荷叶表面同样有非常复杂的纳米级的超微层,所以水在荷叶上摩擦力不大,不会留在荷叶表面。

那么我们现在试一下,左边手机我刚贴了膜,右边手手机没有贴膜,你看有疏油层的水滴会高一点,没有疏油层的水滴会散开。


再用酒精擦拭一下,看到了没有。

和之前没有什么变化。

酒精会溶解疏油层的说法是不对的,实际上疏油层最怕的是磨擦,你看苹果和华为官网,都说了消毒要轻轻擦擦,就是为了减少疏油层的磨损。

当然你如果嫌酒精消毒麻烦,也可以购买专用的紫外线消毒盒,紫外线可以破坏病毒蛋白和核酸,对于新冠病毒同样有效。
作者|郑 勇